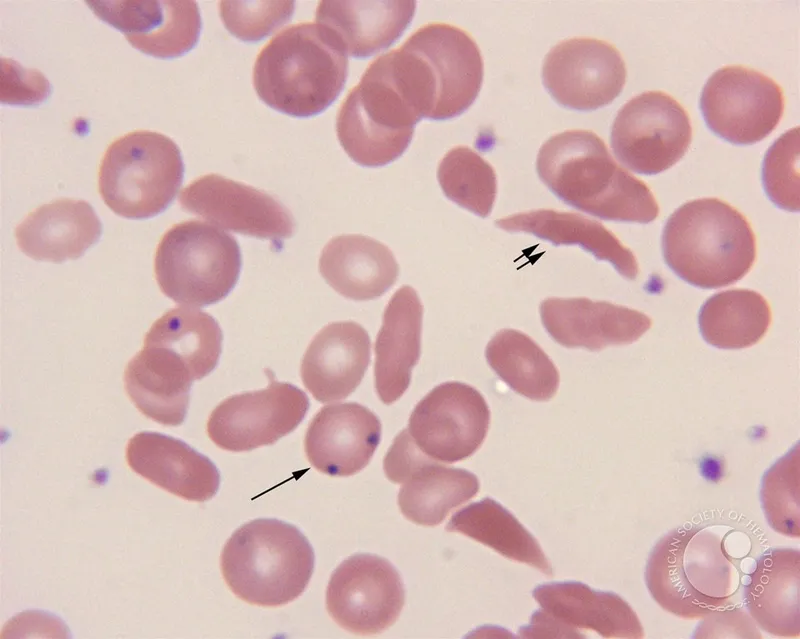
Sickle cells and Howell-Jolly bodies

Hemoglobinopathies - The Hb Hiccups
Genetic disorders of hemoglobin structure (qualitative) or synthesis (quantitative).
- Normal Adult Hb:
- HbA ($\alpha_2\beta_2$): >95%
- HbA2 ($\alpha_2\delta_2$): 1.5-3.5%
- HbF ($\alpha_2\gamma_2$): <2% (post 6 months)
- Types:
- Structural variants: e.g., HbS, HbC, HbE (Qualitative defect)
- Thalassemias: $\alpha, \beta$ (Quantitative defect: $\downarrow$ globin chain synthesis)
- Hereditary Persistence of Fetal Hemoglobin (HPFH)

⭐ HbF ($\alpha_2\gamma_2$) is the predominant hemoglobin in fetal life, has higher oxygen affinity than HbA, and its persistence can be protective in certain hemoglobinopathies.
Sickle Cell Disease - Crescent Crisis Crew
- Etiology: AR; β-globin (Glu6Val) → HbS.
- Pathophysiology: Hypoxia → HbS polymerization → sickling → vaso-occlusion, hemolysis.
- Key Crises & Features:
- Vaso-Occlusive Crisis (VOC): Pain (dactylitis), priapism, stroke.
- Acute Chest Syndrome (ACS):
⭐ Acute chest syndrome, characterized by new pulmonary infiltrate on chest X-ray plus fever and/or respiratory symptoms, is a leading cause of mortality in adult patients with Sickle Cell Disease.
- Aplastic Crisis: Parvovirus B19.
- Splenic Sequestration: Splenomegaly, ↓Hb.
- Chronic Hemolysis: Anemia, jaundice, gallstones.
- Functional Asplenia: ↑Risk of infection (encapsulated organisms).
- Diagnosis: Hb electrophoresis (HbS, ↑HbF, no HbA in HbSS). Smear: Sickle cells, Howell-Jolly.
- Management Principles:
- Prophylaxis: Penicillin (children <5 yrs), folic acid.
- Hydroxyurea: ↑HbF, ↓crises.
- VOC/ACS: Hydration, analgesia, O2 (SpO2 <92%), antibiotics (ACS), exchange Tx (severe).
- Cure: Hematopoietic Stem Cell Transplant (HSCT). 📌 CAST: Chronic organ damage, ACS, Stroke, Thromboembolism.
Thalassemias - Chain Defect Dramas
Quantitative defect in globin chain synthesis (α or β) → chain imbalance, ineffective erythropoiesis, hemolysis.
- α-Thalassemia: ↓ α-chain synthesis.
- Excess γ (fetus) → Hb Bart's ($γ_4$, hydrops fetalis).
- Excess β (adult) → HbH ($β_4$, HbH disease).
- Spectrum: Silent carrier → α-trait (mild anemia) → HbH disease (mod-severe anemia, golf-ball cells) → Hb Bart's (lethal). 
- β-Thalassemia: ↓ β-chain synthesis. Excess α-chains precipitate. ↑HbF, ↑HbA2.
- Minor (Trait): Mild microcytic anemia.
⭐ In $\beta$-thalassemia trait (minor), HbA2 levels are characteristically elevated (typically >3.5%), a key diagnostic marker differentiating it from iron deficiency anemia.
- Intermedia: Moderate anemia.
- Major (Cooley's): Severe transfusion-dependent anemia, iron overload, "chipmunk facies", "hair-on-end" X-ray.
- Minor (Trait): Mild microcytic anemia.
- Dx: CBC (microcytic, hypochromic, ↑RDW), Hb electrophoresis/HPLC.
- Rx: Genetic counseling; transfusions, iron chelation (major/severe intermedia).
 📌 α: 4 gene deletion = Bart's (hydrops). β-minor: ↑HbA2. β-major: Big Spleen/Bones.
High‑Yield Points - ⚡ Biggest Takeaways
- Sickle Cell Disease (SCD): Autosomal recessive, HbS (β-globin point mutation); causes vaso-occlusive crises. Hydroxyurea ↑ HbF.
- Thalassemias: Quantitative globin synthesis defect. α-thalassemia (gene deletions), β-thalassemia (point mutations).
- β-Thalassemia Major: Severe microcytic anemia, hepatosplenomegaly, requires lifelong transfusions & iron chelation.
- Key Labs: ↑ HbA2 in β-thalassemia trait; ↑ HbF in β-thalassemia major.
- HPLC is gold standard for diagnosis of hemoglobinopathies.
- Aplastic crisis in SCD is commonly triggered by Parvovirus B19 infection.
Unlock the full lesson and continue reading
Signup to continue reading this lesson and unlimited access questions, flashcards, AI notes, and more